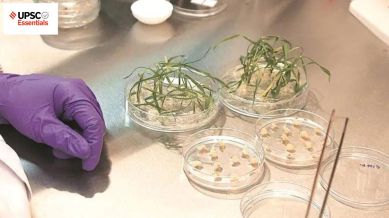
UPSC Mains answer practice — GS 3 (Week 68)

UPSC Essentials brings to you its initiative for the practice of Mains answer writing. It covers essential topics of static and dynamic parts of the UPSC Civil Services syllabus covered under various GS papers. This answer-writing practice is designed to help you as a value addition to your UPSC CSE Mains. Attempt today’s answer writing on questions related to topics of GS-3 to check your progress.
Discuss how biotechnology can be harnessed for the economic development of the country.
How has Pradhan Mantri Jan Dhan Yojana (PMJDY) accelerated financial inclusion? Discuss the measures which can address the barriers to financial inclusion.
Introduction
— The introduction of the answer is essential and should be restricted to 3-5 lines. Remember, a one-liner is not a standard introduction.
— It may consist of basic information by giving some definitions from the trusted source and authentic facts.
Body
— It is the central part of the answer and one should understand the demand of the question to provide rich content.
— The answer must be preferably written as a mix of points and short paragraphs rather than using long paragraphs or just points.
— Using facts from authentic government sources makes your answer more comprehensive. Analysis is important based on the demand of the question, but do not over analyse.
— Underlining keywords gives you an edge over other candidates and enhances presentation of the answer.
— Using flowcharts/tree-diagram in the answers saves much time and boosts your score. However, it should be used logically and only where it is required.
Way forward/ conclusion
— The ending of the answer should be on a positive note and it should have a forward-looking approach. However, if you feel that an important problem must be highlighted, you may add it in your conclusion. Try not to repeat any point from body or introduction.
— You may use the findings of reports or surveys conducted at national and international levels, quotes etc. in your answers.
Self Evaluation
— It is the most important part of our Mains answer writing practice. UPSC Essentials will provide some guiding points or ideas as a thought process that will help you to evaluate your answers.
QUESTION 1: Discuss how biotechnology can be harnessed for the economic development of the country.
Note: This is not a model answer. It only provides you with thought process which you may incorporate into the answers.
Introduction:
— The Centre unveiled its BioE3 (Biotechnology for Economy, Environment and Employment) policy. It appears to be a routine attempt to create incentives and opportunities to energise growth in the biotech sector.
— The policy seeks to achieve this by harnessing the power of biotechnology, and developing new manufacturing methods that replicate, or mimic, processes found in natural biological systems.
Body:
You may incorporate some of the following points in the body of your answer:
— Biotechnology is the science of modifying biological organisms and processes to create desired goods or applications. It encompasses fields such as genomics, genetic engineering, synthetic biology, bioinformatics, and gene therapy.
— Knowledge in these areas has been used to identify remedies for genetic illnesses or to create new plant kinds with desirable characteristics. So far, biotechnology-based solutions have been mostly used in medical science and agriculture.
— Traditional products such as synthetic clothing, plastics, meat or milk, and gasoline can be replaced by more environmentally friendly alternatives derived from modern biology. Similarly, several industrial chemical processes can be substituted with organic, less polluting biological processes.
— For example, a procedure known as precise fermentation can be used to generate animal-free milk that has the same taste, texture, and nutritional benefits as natural milk. Benefits include a lower carbon impact, more access, improved nutritional value, and expanded availability.
— Traditional chemically produced plastics, which pose a significant environmental risk, can be replaced with a variety of biodegradable bioplastics such as polylactic acid. These bioplastics are created from renewable and recyclable biological elements, such as maize starch or sugarcane, rather than hydrocarbons, which are the source of standard plastics.
— In synthetic biology, unique organisms with specific properties or biochemicals such as proteins and enzymes can be created from scratch to execute desired roles. Organs can be created in laboratories via a process known as organogenesis or organ engineering. This could end the need for organ donors for transplants.
Conclusion:
— However, recent advances in gene editing technologies, protein synthesis, and the ability to grow specific enzymes using genetically modified microorganisms, combined with improved data processing capabilities and the use of artificial intelligence, have opened up new avenues for biotechnology.
— In the coming years, these technologies are projected to change the economy and existing procedures. The BioE3 policy thus attempts to prepare India for the future. The approach is unlikely to produce an economic payoff in the foreseeable future. However, the goal is to establish competences, stimulate research, educate and train young talent, and participate in the technological development process so that India will be well-positioned to gain when the innovations mature.
Points to Ponder
Some examples of gene editing technologies
What are biodegradable bioplastics?
Read about some biotechnology-based solutions for agriculture
Related Previous Year Question
How does e-Technology help farmers in production and marketing of agricultural produce? Explain it. (2023)
QUESTION 2: How has Pradhan Mantri Jan Dhan Yojana (PMJDY) accelerated financial inclusion? Discuss the measures which can address the barriers to financial inclusion.
Note: This is not a model answer. It only provides you with thought process which you may incorporate into the answers.
Introduction:
— The Pradhan Mantri Jan Dhan Yojana (PMJDY) was launched on August 28, 2014, as a nationwide financial inclusion initiative. It has been “paramount in boosting financial inclusion and giving dignity to crores of people, especially women, youth, and marginalised communities” for the past ten years.
— The establishment of PMJDY delivered an extraordinary boost to the government’s financial inclusion effort on a scale never witnessed before. The PMJDY’s primary goal was to open Basic Savings Bank Accounts for unbanked citizens. PMJDY accounts did not require a minimum balance and generated interest on deposits in the same way as normal accounts do.
Body:
You may incorporate some of the following points in the body of your answer:
How has PMJDY accelerated financial inclusion?
— Financial inclusion has been a fundamental instrument used by policymakers and governments around the world to reduce inequities, improve the lifestyles of people at the bottom of the pyramid, and boost growth.
— More than 80% of persons now have a formal financial account, up from approximately 50% in 2011.
— The gender gap in account ownership has been greatly decreased by basic savings bank deposit accounts for individuals.
— It has been useful for identifying leaks in the transfer and transferring benefits directly. It has also assisted with digitalisation, e-commerce, and payment systems.
Measures to address the current barriers to financial inclusion
— There is a need to strengthen the ecosystem and enablers that support financial inclusion. We must focus on boosting private-sector involvement in financial inclusion through partnerships.
— There is a need to expand cost-effective access to financial products and services such as micro-insurance and credit.
— To retain consumer trust in new and sophisticated digital products, it is necessary to focus on enhancing the consumer protection framework, as well as developing inclusive legislation and policies that strike a delicate balance between protection and innovation.
— The PMJDY consists of people who are new to the financial system. Many of them have variable income streams. Many have little money to save, and their needs differ greatly from those of typical customers. All of this necessitates a customer-centric product design that considers consumers’ lifecycle needs at all stages.
Conclusion:
— So far, banks have opened around 53 million PMJDY accounts with a balance of Rs 2.31 lakh crore, up more than thrice from 14.7 crore accounts with deposits of Rs 15,670 crore in March 2015. This has been predominantly driven by public sector banks, which comprise approximately 78% of these accounts.
— The average account balance in PMJDY accounts has increased by more than four times, reaching Rs 4,352 in August 2024, from Rs 1,065 in March 2015.
(Source: 10 years of Jan Dhan: How the scheme has had a transformative impact on financial, banking sector by Harikishan Sharma, PM Jan Dhan Yojana has accelerated financial inclusion, reduced inequalities by Soumya Kanti Ghosh)
Points to Ponder
Features of PMJDY
What is financial inclusion?
Related Previous Year Questions
Examine the main provisions of the National Child Policy and throw light on the status of its implementation. (2016)
The Right of Children to Free and Compulsory Education Act, 2009 remains inadequate in promoting incentive-based systems for children’s education without generating awareness about the importance of schooling. Analyse. (2022)
UPSC Essentials: Mains answer practice — GS 1 (Week 67)
UPSC Essentials: Mains answer practice — GS 1 (Week 66)
UPSC Essentials: Mains answer practice — GS 2 (Week 66)
UPSC Essentials: Mains answer practice — GS 2 (Week 67)
UPSC Essentials: Mains answer practice — GS 3 (Week 67)
UPSC Essentials: Mains answer practice — GS 3 (Week 66)
Subscribe to our UPSC newsletter and stay updated with the news cues from the past week.
Stay updated with the latest UPSC articles by joining our Telegram channel – IndianExpress UPSC Hub, and follow us on Instagram and X.
https://www.youtube.com/watch?v=MNesF36gKu4?si=CFbs5LfRdA-FR5k5